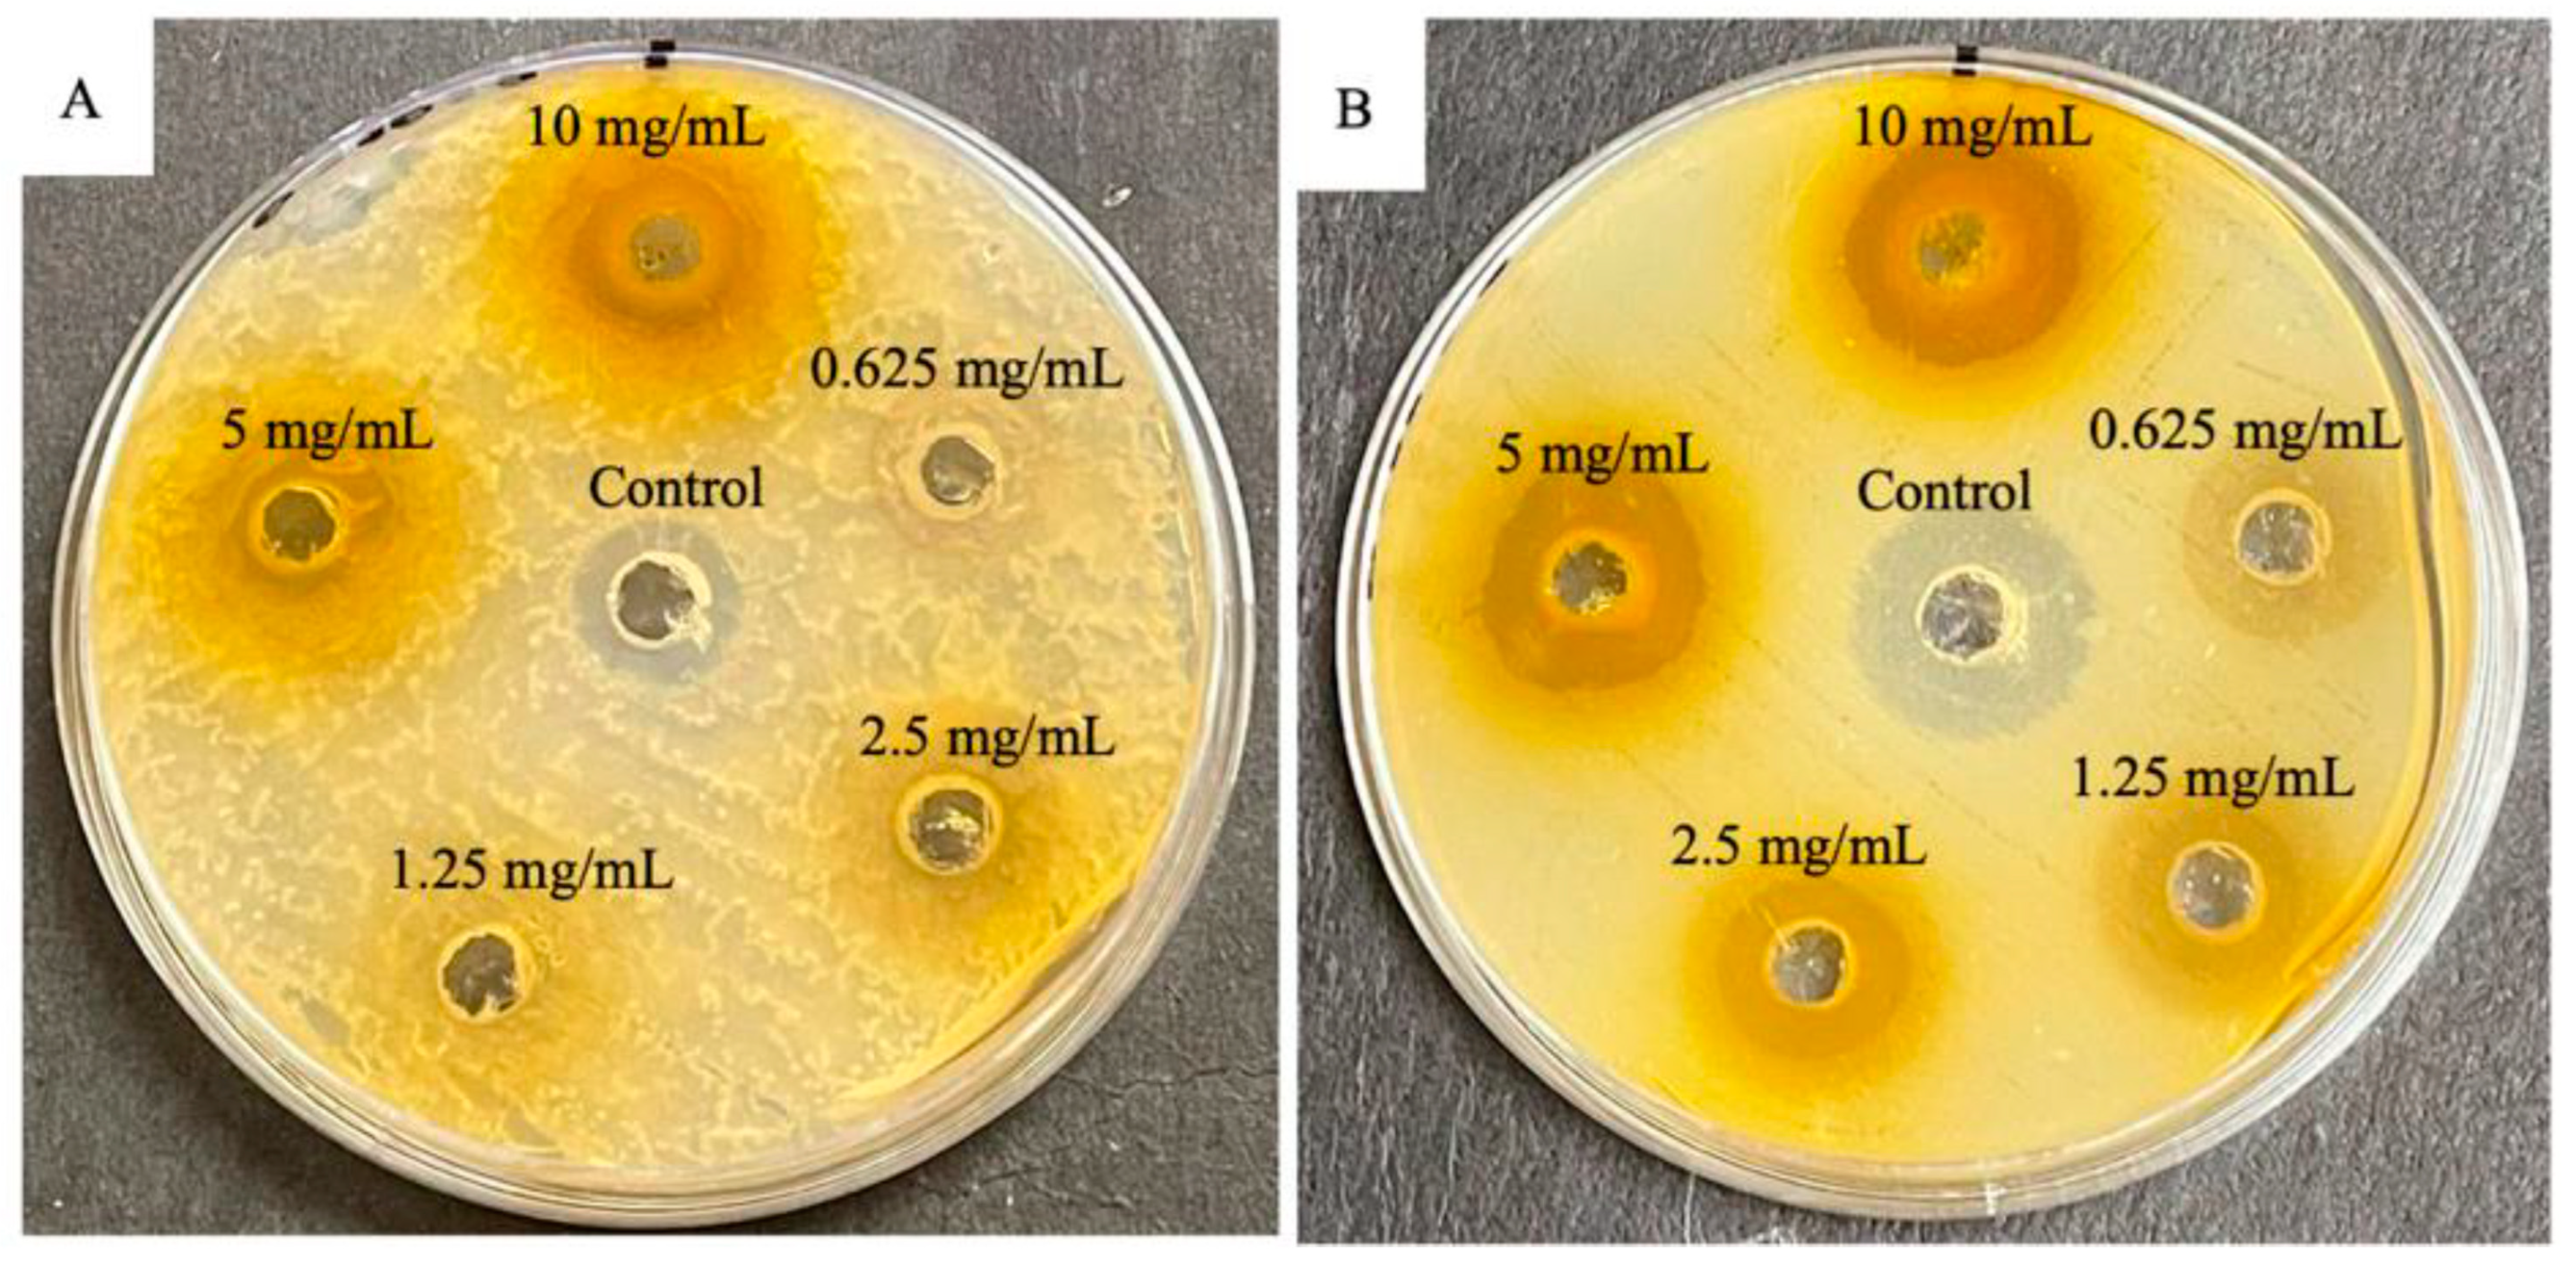
Engproc 87 00058 g002

Abstract
Currently, multidrug-resistant (MDR) bacteria are a global problem, which requires modern approaches and effective pharmaceutical agents. Substances isolated from nature sources have a strong potential in combating highly virulent and antibiotic-resistant microorganisms, including within the ESKAPE group (Enterococcus faecium, Staphylococcus aureus, Klebsiella pneumoniae, Acinetobacter baumannii, Pseudomonas aeruginosa, and Enterobacter spp.). One of these substances is mangiferin, the bioactive compound obtained from parts of Mangiferin indica L. Mangiferin has a low aqueous solubility, which causes low activity and requires additional modification or delivery system to increase its concentration in the cell. Many studies show that it has multiple biological effects and can be used as an antioxidant or an anticancer agent, and it can exhibit antibacterial properties. Extracts obtained from plant parts show high efficacy in low doses against the ESKAPE group and other strains. This makes mangiferin a possible candidate as a strong agent against bacterial infections. The mechanisms underlying the action of mangiferin on bacterial cells are poorly understood. This review summarizes studies confirming the antibacterial properties of mangiferin both in its native form and using delivery systems.
1. Introduction
Mangiferin (C-2-β-D-glucopyranosyl-1,3,6,7-tetrahydroxyxanthone) is a natural polyphenol with various biological activities and therapeutic effects. In its pure form, it is a yellow crystalline powder. This compound is obtained from mango stalks, leaves, barks, fruits, their peel, or seeds. It is also found in other plants of the Anacardiaceae and Gentianaceae families, as well as in Honeybush (Cyclopia sp.), which is popular in the southern region [1]. Mango pulp contains less mangiferin than the peel, bark, and leaves of the plant [2]. The content of the biologically active substance can vary greatly depending on the maturity or variety of the fruit, as well as the extraction of it from bark and leaves, which can be an excellent option for obtaining mangiferin from natural sources [3]. In addition to mangiferin, mango contains its derivatives, isomangiferin and homomangiferin, which account for 10% of the total phenols [4].
In addition to natural sources of mangiferin, today, there are methods of chemical synthesis of a similar compound, mangiferin aglycone, which is more stable [5,6]. It is worth noting that mangiferin aglycone has more pronounced radioprotective effects, which was shown in the study of radiation-induced damage to normal human intestinal epithelial cells (HIECs) [7].
All polyphenols are antioxidants, but mangiferin’s special structure, including eight hydroxyl groups, makes it an extremely powerful antioxidant. The structure of the molecule includes a C-glycosyl bond, which, in conjunction with hydroxyl groups, provides it the ability to absorb free radicals.
The chemical synthesis of mangiferin occurs through the formation of an O-glycosidic bond via Friedel–Crafts reactions between a glycosyl donor and an electron-rich aromatic compound, followed by the formation of an aryl-C-glycoside. Mangiferin is synthesized by the reaction of the aglycone 1,3,6,7-tetrahydroxyxanthone with R-acetobromoglucose and following hydrolysis [4,8].
Mangiferin was, firstly, isolated in 1908 as a dye from the mango tree (Mangiferin indica L., Anacardisaceae), and its structure was confirmed in the 1960s. At the beginning of the 21st century, interest in its wide range of properties significantly increased. At the moment, there are several clinical trials confirmed the action of mango on cardiovascular health (NCT03203187), blood pressure and blood glucose (NCT04057495), microcirculation and endothelial function (NCT02511899), and cognitive function and cerebral blood flow (NCT05580146). Zynamite® (Mangifera indica leaf extract) was launched in 2018. It is now a market product, and it has been established that its action is mediated by the partial inhibition of COMT (Catecol-O Metil-Transferase), which is a key enzyme that degrades dopamine, a neurotransmitter that modulates cognitive function, including working memory, planning, and attention.
The effects of mangiferin were mainly studied on cell cultures and animals. It is known that the use of plants or parts of plants containing mangiferin is a traditional medicinal practice in East Asian countries. Also, the drug Vimang® is commercially produced in Cuba [9].
Like many other polyphenols, mangiferin is poorly soluble in water, and its bioavailability is very low. To achieve better solubility, bioavailability, and efficiency, both mangiferin derivatives (mangiferin aglycone) and phospholipid complexes were synthesized [10]. However, approaches to developing various delivery systems are also being considered. Table 1 presents some of the mangiferin-loaded nanocarriers, as well as the method of their preparation and the results obtained using them.

Table 1.
The various types of mangiferin-loaded nanocarriers, along with their excipients, method of preparation, and outcomes. Adapted from [11] under the terms of the CC-BY 4.0 license. Copyright 2023, The Authors. Published by MDPI AG.
Mangiferin has been extensively studied as an antioxidant [12,13], antidiabetic [7,14], and anticancer agent [9,15,16], and it is also known to have antimicrobial and immunomodulatory effects [16]. The known data suggest that mangiferin may be a future low-cost compound for improving and maintaining health. In addition, its anticancer mechanism makes it a candidate as an anticancer drug. Its synergistic effects with some anticancer drugs, such as doxorubicin, etoposide, and cisplatin, have been documented [15].
The problem of combating multidrug-resistant (MDR) strains is an acute task, especially in recent years. The reason for the growth of resistant bacteria lies in the excessive use of antibiotics not only in healthcare but also in agriculture. A special group of MDR strains includes ESKAPE bacteria, which cause hospital-acquired infections in patients with weakened immunity. Such strains arise when the dose of the prescribed antibiotic is incorrectly determined, or the patient’s attitude to the doctor’s recommendations is negligent; for example, when the patient does not complete the course of treatment. The emergence of mutations and natural selection creates strains resistant to many antibiotics, and horizontal gene transfer increases the rate of spread of drug resistance. The development of new antibiotics is insufficient due to these problems. Therefore, there is a need to search for other ways to combat bacterial infections. The use of compounds from natural sources can help to solve this problem.
A few in vitro studies have shown that mangiferin also has a synergistic effect when used with existing antibiotics and/or exhibits independent inhibitory activity against some strains of ESKAPE group bacteria. Various methods are used to improve the antibacterial properties of secondary metabolites, such as loading them into polymer matrix-based delivery systems. In this article, we review the results of studies of the antibacterial activity of pure and encapsulated mangiferin.
2. Biological Activity of Mangiferin and Its Main Mechanisms
In traditional medicine in East Asian countries, the use of plants containing mangiferin is common for the treatment of several diseases such as diabetes, infection, and cancer [17]. The most common source is the mango, or Mangifera indica. This plant is used in India as a food supplement, in China for the prevention and treatment of several diseases such as neuropathic pain and ulcers, and in Cuba [10,18,19]. Another source is Salicia chinesis (saptarangi), which has a mangiferin content as high as mangoes. It was used for its antidiabetic and antioxidant properties. In China, the root of Dobinea delavayi (Baill.) is also used as an antitumor agent [20]. In South Africa, mangiferin is consumed with Honeybush tea, obtained from Cyclopia sp. It contains up to 4% mangiferin (dry weight) [10].
Mangiferin has poor lipophilicity and hydrophilicity. The solubility in water is 0.16 mg/mL. All this limits the bioavailability of the active substance [21]. To improve solubility, mangiferin complexes with phospholipid were developed. The results of the study showed an increase in the activity of the complex compared to pure mangiferin. The bioavailability of mangiferin increased by 9.75 times, and the half life also increased (up to 3 h) [11]. Another way to increase bioavailability and the content of mangiferin in the blood plasma is the oral administration of mangiferin as a part of a polyherbal formula. Competitive inhibition between mangiferin and other glycosides included in the formulation can reduce degradation and increase the concentration of mangiferin in the intestine, which leads to an increase in its bioavailability [22]. In order to improve bioavailability and to increase the concentration of mangiferin not only throughout the body but also inside tumors, innovative delivery systems are being developed.
Mangiferin has many biological effects that can be used in the treatment of diseases of various origins (Figure 1). In this section, we briefly consider some of the effects and mechanisms of its activity.

Figure 1.
Health benefits of mangiferin. Reproduced from [23] under the terms of the CC-BY 4.0 license. Copyright 2024, The Authors. Published by John Wiley & Sons, Inc.
2.1. Antioxidant Effect
It is known that oxidative stress is one of the factors in the development of cancer. It occurs when the detoxification system in the body does not work, and there are not enough antioxidants. Hence, there is a high level of reactive oxygen species (ROS). In the process of metabolism in the human body, free radicals are formed, which leads to the oxidation of biological macromolecules, especially DNA.
One of the properties of mangiferin is the ability to activate the enzyme catalase. Catalase is an enzyme that, when exposed to oxygen, converts H2O2 into water and oxygen. H2O2 is a strong oxidizer and can cause severe damage. Mangiferin directly increases the efficiency of the enzyme by binding to the active center [24]. This reduces oxidative damage and does not activate the pathways that contribute to the development and survival of cancer.
In addition to the regulation of the detoxification pathways, mangiferin, being an antioxidant, is able to directly restrict ROS formation. Studies revealed that the antioxidant capacity of mangiferin is equal to or stronger than the antioxidant activity of other known antioxidants such as vitamin C, vitamin E, and β-carotene [7]. Thus, the results obtained by the DPPH radical neutralization assay showed potent dose-dependent activity (IC50 17.6 µg/mL). However, this result was lower than that of vitamin C used as a control (IC50 11.9 µg/mL) [3]. The crude methanol and hexane extracts from M. indica leaves also showed quite high results of 50% DPPH radical inhibition of 12.71 µg/mL and 19.53 µg/mL, respectively [25]. The antioxidant effect is due to the presence of hydroxyl groups, which serve as metal chelators and neutralizers of hydrogen donors. They are abundant in flavonoids, terpenes, and phenols, which are found in large quantities in the leaves of M. indica. When the biological activity of a new isoform of mangiferin—Ceibinin—was compared with mangiferin, the basal level of intracellular reactive oxygen species (ROS) was tested, as well as the ability to modulate the increase in ROS induced by hydrogen peroxide in cultured HeLa cells. The inhibitory effects of both compounds were pronounced after 24 h. These demonstrated high antioxidant potential, such that, after 24 h, the effect of peroxide (100 μM) was reversed by 6.25 μg/mL (14.8 μM) of each compound. The antioxidant activity is suggested as a consequence of the presence of phenolic groups in the structure of the molecules [26].
In the study of polyphenols as therapeutic agents with neuroprotective effects in experimental models of brain injury and neurodegenerative diseases, ROX levels were assessed. This study aimed to investigate the neuroprotective properties of morin and mangiferin against Aβ oligomers in cultured cortical neurons and organotypic slices. It was determined whether neuronal oxidative stress and cell death could be reduced in neurons treated with oligomer Aβ in vitro and in organotypic cortical slices upon addition of the two polyphenols. ROS levels were attenuated by 1 μM of morin and 1 μM of Mng (107 ± 3 and 110 ± 4%, respectively; ANOVA, p < 0.01; Bonferroni post-hoc A β vs. A β + morin, p < 0.01; A β vs. A β + morin, p < 0.01; A β vs. A β + Mng p < 0.05), showing an effective antioxidant capacity against Aβ-induced oxidative stress [27].
The results indicate a protective effect of mangiferin against MeHg-induced toxicity, which may be due to its free-radical scavenging ability. This, in turn, was shown to downregulate mitochondrial apoptotic-signaling pathways [28].
SOD is a group of metalloenzymes that catalyze the dismutation of superoxide radicals into hydrogen peroxide and molecular oxygen. In this way, SOD prevents the formation of free radicals such as hydroxyl radical and reduce oxidative stress. CAT (catalase) is an enzyme that catalyzes the degradation of hydrogen peroxide. Just like SOD, it plays a key role in the antioxidant mechanism of cells [29]. The function of SOD and catalase, enzymes that combat oxidative stress, was evaluated in rats with parkinsonism induced by 6-OHDA. The activity of these enzymes was decreased, indicating increased oxidative stress. Administration of mangiferin (45 μg) for 28 days significantly increased the function of both SOD and catalase in rats with Parkinson’s disease. The study also notes the possibility of synergistic action of mangiferin, in combination with levodopa [30].
The reduction of oxidative stress in the prevention of lung carcinogenesis was also reported, as the levels of antioxidant enzymes decreased in the group receiving benzopyrene (BaP). However, in animals administered with both benzopyrene and mangiferin, antioxidant enzymes increased [31].
If the mechanisms of suppression of excessive oxidation and DNA repair are disrupted due to active accumulation of reactive oxygen and nitrogen species, there is a risk of homeostasis disturbance. This, in turn, leads to damage to gene expression and the emergence of various forms of cancer [23].
2.2. Anticancer Effect
One of the ways to affect cancer cells is to arrest the cell cycle. Mutated cells are unable to undergo mitosis because the cycle has a number of checkpoints that prevent the replication of damaged or mutated DNA. The G2/M checkpoint occurs during the transition from G2 to mitotic entry. Rapid cell growth occurs in the G2 phase, which precedes preparation for mitosis. Cell progression from the G2/M checkpoint occurs only in the absence of DNA damage signals. Mangiferin exhibits antileukemic and prophylactic effects in HL-60 leukemia cells by the induction of cell cycle arrest in the G2/M phase. The cdc2–cyclinB complex, often overexpressed in malignant cells, enhances entry into mitosis in eukaryotic cells. At the elevated concentrations, mangiferin suppresses Chk1 and cdc25C mRNA expression and induces Wee1 mRNA expression in a dose-dependent manner [16]. The results indicate that inhibition of the ATR-Chk1 stress DNA damage pathway by mangiferin is responsible for cell cycle arrest.
The key mechanism of the anticancer activity of mangiferin is its effect on the Nrf2/HO-1 axis. Typically, the transcription of the Nrf2 gene is suppressed Kelch-like ECH-associated protein-1 (KEAP-1). Nevertheless, factors such as oxidative stress, certain dietary elements, and synthetic compounds can induce Nrf2 transcription. Accumulating in the nucleus, the protein forms a heterodimer, which, in turn, triggers a signaling pathway via ARE to initiate transcription of phase II detoxification enzymes: NAD(P)H:quinine reductase (NQO1), glutathione S-transferase (GSH), and heme oxygenase (HO-1). As evidenced by a study of the properties of mangiferin on H2O2-treated ARPE-19 cells, mangiferin activates Nrf2 protein expression and increases its phosphorylation (p-Nrf2) with predominant expression in the nucleus. These results are similar to the action of resveratrol, a known activator of Nrf2. An increase in protein expression and enzymatic activity of HO-1, a major downstream factor of Nrf2, was also observed in cells co-treated with H2O2 and mangiferin compared to the exposure of H2O2 alone. An additional interesting observation is that the results were not observed in cells treated with mangiferin alone. This indicates that Nrf2/HO-1mangiferin activates Nrf2/HO-1 signaling only under conditions of oxidative stress [32].
Mangiferin enhances Nrf2 protein accumulation, increases Nrf2 binding to ARE, regulates NQO1 expression, which helps suppress oxidative stress by reducing ROS levels. Importantly, Nrf-ARE signaling can provide protection against agents that are chemotherapeutic for normal cells. Mangiferin appears to be able to differentiate between malignant cells and healthy cells, promoting Nrf2 activation in healthy cells but not in cancer cells. It is known that increased expression of Nrf2 in cancer cells may contribute to resistance to therapy [15].
One study indicates that mangiferin has a selective effect in the activation of Nrf2 in healthy and cancer cells. However, there are no more recent studies confirming this fact [33].
2.3. Antibacterial Activity
Many studies have shown the antibacterial activity of mangiferin against gram-positive and gram-negative bacteria. However, it can be assumed that mangiferin, which is a polyphenol, can damage the bacterial membrane, inhibit virulence factors, and suppress biofilm formation [3].
2.3.1. Membrane Interaction Mechanism
It is known that xanthone C-glucosyls can damage cell membranes and reduce bacterial protein synthesis. Mangiferin, which is found in high concentration in the leaves of M. indica L., belongs to this group of compounds [34]. In addition, the good penetration of mangiferin through the membrane may be due to its chemical structure and polarity, since the presence of polar groups reduces solubility and promotes diffusion through cell membranes. Additionally, the content of highly reactive hydroxyl groups, as well as moieties with a high affinity for protein binding, contributes to the activity of phenolic compounds [3]. One of the proposed mechanisms of action of mangiferin is the interaction of its hydroxyl groups with the alkyl chains of bacterial lipids, which allows mangiferin to penetrate the bacterial cell [35]. According to the experimental results, the rapid penetration of mangiferin into the bacterium disrupted the integrity of the cytoplasmic membrane, which led to a rapid loss of intracellular components within a short period of time [3].
One of the methods of an alternative strategy to deal with gram-negative bacteria is the conjugation of antibacterial agents with siderophore molecules. They form complexes with iron ions used by bacteria for proliferation. When absorbing such conjugates, the bacterium passes the antibacterial substance inside, which leads to its death. Mangiferin can be considered a potential agent for conjugation due to the special structure of the molecule. The mangiferin compound has a long, non-polar, hydrophobic alkyl-saturated chain, which allows it to be embedded in the membrane [25]. It is also known that bacteria are capable of incorporating siderophore conjugates into their cytoplasm or periplasm. The mangiferin molecule can bind to the siderophore and penetrate the bacterial cell through the membrane bilayer. More research should be done in these directions, since no mechanism has been confirmed [28].
2.3.2. Antibiofilm Activity
Formation of bacterial biofilms leads to decreased treatment efficacy. A study of mangiferin as an anti-film agent was conducted using the formation of S. mutans films in dental plaque as an example. Biofilms help in fixing bacteria on the surface of teeth, are a reservoir for carbohydrates and a defense mechanism against antibacterial agents. Glucansucrases provide binding elements that create a favorable environment for biofilm formation. By inhibiting the ability of glucansucrases to synthesize glucan, the formation of polysaccharides will decrease, and the formation of bacterial plaque will be disrupted. The study reports the inhibitory potential of mangiferin on glucan synthesis by glucansucrases. Using a computational approach, it was shown that mangiferin binds to amino acids of domains A and B of glucansucrases. These domains contain the catalytic sites of the enzyme. The presence of mangiferin hindered S. mutans from forming colonies, which in turn decreased the bacterial ability to develop biofilms when adhesive glucan is not available. Mangiferin also significantly suppressed the expression of the virulence genes gtfB, gtfC, and gtfD, which are involved in biofilm formation [36].
2.3.3. Quorum Sensing Disruption
In continuation of the discussion of antibacterial mechanisms of mangiferin, attention should be paid to the regulation of quorum sensing involved in biofilm formation and the regulation of a favorable environment for cells. In a study on the inhibition of S. mutans biofilms, mangiferin reportedly suppressed the comDE gene. This gene is involved in the quorum-sensing system, regulating the expression and competence of glucanotransferase enzymes. Reports indicate that S. mutans uses this gene to respond to changes in the oral environment by transducing a membrane signal. Suppression of comDE gene expression has a profound effect on cell wall integrity and adhesion loss [36].
In another study on the effect of mangiferin on quorum sensing, the inhibition of LasR was studied in silico and in vitro. According to the results of molecular docking, mangiferin had a good docking score of −10.2 kcal/mol against LasR and a higher negative free energy of binding (−42.24 ± 3.94 kcal/mol) than azithromycin against LasR (reference). Also, the LasR–mangiferin complex showed good values of docking stability and reliability. In in vitro tests, mangiferin showed the highest percentage of inhibition (77.99–88.54%) of cell attachment. This result was maintained for all tested concentrations. The highest percentage of inhibition was achieved by mangiferin (70.61%) at 1/8 MIC [37].
3. Antibacterial Activity Against ESKAPE Bacteria
ESKAPE is a group of gram-positive and gram-negative bacteria that are the main cause of bacterial infections in healthcare facilities in patients with weakened immune systems. The group includes Enterococcus faecium, Staphylococcus aureus, Klebsiella pneumoniae, Acinetobacter baumannii, Pseudomonas aeruginosa, and Enterobacter spp. The danger of these strains is their multiple drug resistance (MDR). Due to the peculiarities of their habitat, these bacteria were able to develop the most amazing mechanisms capable of inhibiting various classes of antibiotics. Very often, the emergence of such lines can be associated with the onset of use of a specific class of antibiotics or with the use of broad-spectrum antibiotics. If the prescriptions for taking antibacterial drugs are not followed, there is an opportunity to form cell lines that can counteract the drug and reduce the effectiveness of the therapy. These problems are also associated with an additional burden on the healthcare system and require increased funding [38].
Bacteria use various counteraction mechanisms that reduce the effectiveness of drugs. For example, they can produce special enzymes that destroy the active substance molecules and, thus, inhibit the action of the antibiotic. This is especially common in gram-negative bacteria. The most well-known example is the appearance of β-lactamases in bacteria, which are capable of destroying the β-lactam ring, resulting in a resistance to β-lactam antibiotics (penicillins and cephalosporins). Enzymes can also modify key structures of the molecule. This is how the mechanism of resistance to aminoglycosides works: enzymes catalyze specific modifications of the hydroxyl or amino group of the aminoglycoside, reducing antibacterial activity [39].
Another way to counteract is to change or modify bacterial structures. The mecA gene encodes a PBP protein with low affinity for β-lactams, which makes bacteria resistant to β-lactam agents [40].
Reducing the penetration and accumulation of antibiotics is also an effective mechanism for counteracting antibacterial agents. Hydrophilic agents, carbapenems, and fluoroquinolones, which penetrate the cell using special protein channels—porins are particularly affected. Bacteria have also learned to pump out antibiotics. This occurs through efflux pumps [39].
It is also known that bacteria often form biofilms, which are special structures where cells can differentiate and perform different functions. Often, several types of bacteria coexist in biofilms, which also complicates the use of antibacterial drugs. Biofilms serve as a good protective formation, where cells are enclosed inside a matrix. Biofilms limit the penetration of antibiotics, provide differential metabolic activity, and promote increased horizontal gene transfer, which leads to the emergence of new resistant lines [41].
Nika Kuchuk’s group [35] investigated the content of bioactive substances in mango peel. It was determined that mango peel contains more bioactive compounds, such as polyphenolic compounds, vitamins (E, C), and mangiferin, which is the main polyphenolic compound of mango, than in the pulp. Tests were also conducted for antibacterial activity against gram-positive (S. aureus, B. cereus) and gram-negative (E. coli, P. aeruginosa) bacteria. Mango peel extract showed inhibition of bacterial growth. Ethanol extracts of mangiferin have the most pronounced effect. Antimicrobial activity was tested by the Kirby–Baker disk diffusion, with ciprofloxacin as a positive control, and by the microbroth dilution method, but only for samples that had undergone the disk diffusion method.
B. cereus was found to be the most susceptible. The largest inhibition zone was detected when exposed to the ethanol extract from fresh peel. The second-most sensitive strain was E. coli, which also showed a large inhibition zone when the ethanol extract was added. Aqueous extracts were the least sensitive in all cases. All extracts obtained from mango peel successfully inhibited the growth of the tested bacterial species, which indicates the possibility of further use as effective natural antibacterial agents.
For E. coli and P. aeruginosa, the inhibition of more than 90% was achieved at a concentration of a 5.0 mg/mL aqueous solution. Inhibition of more than 50% was obtained for four of the nine extract samples with the lowest concentration of 0.05 mg/mL. Complete inhibition of the gram-positive bacterium B. cereus was achieved at the highest-tested concentration for all extracts. However, even at lower concentrations of the extracts, the bacterium was susceptible to the action of the extracts.
The second gram-positive bacterium tested was S. aureus, which was very sensitive to all mango peel extracts after 12 h of incubation. However, complete resistance of S. aureus was observed at the lower concentrations of extracts and longer exposure times, indicating that S. aureus can adapt to bioactive compounds with antimicrobial potential in extracts upon long-term exposure.
Another study [42] examined the efficacy of mango leaf extracts as a function of leaf maturation. Additionally, mangiferin content was measured in leaves at different stages as the main bioactive substance. The ethanol extracts were then tested for gram-positive and gram-negative bacteria using broth dilution and agar well-diffusion methods.
A decrease in mangiferin content was shown with leaf maturation, which in turn affected the antibacterial activity of the solutions obtained. Extracts from younger leaves demonstrated superior antibacterial properties compared to those from older leaves, as indicated by reduced minimum inhibitory concentrations and increased inhibitory zones. It can be concluded that younger mango leaves, especially dark reddish–brown and young yellow leaves, are more preferable for the treatment of bacterial infections. The authors also noted that the differences in minimum inhibitory concentrations (MICs) values between the different research groups could be partly explained by the differences in the microorganisms studied, since the selective nature of the action of isolated mangiferin was found.
It is worth noting that the leaf extracts at the two youngest stages (dark reddish-brown and yellow) showed higher activity against S. aureus than purified mangiferin, as evidenced by the lower MICs (1.95 vs. 3.91 μg/mL). It can be concluded that the mangiferin content influences the antibacterial effect of young leaves against B. cereus, B. subtilis, S. aureus, E. coli, and S. typhimurium.
Among all the bacteria examined, S. aureus ATCC25923 exhibited the highest sensitivity to both mango leaves and mangiferin, demonstrated by its lowest MIC values. In contrast, P. aeruginosa ATCC 9027 displayed the greatest resistance, as the MICs of all leaf extracts and mangiferin were consistently higher than those for other bacterial strains. The effect of the extracts may be mediated by the content of other compounds, as mangiferin alone did not show any inhibition against this bacterium. Therefore, the effects cannot be attributed to a single bioactive substance, and the maximum effect is achieved by the synergistic action of the various ingredients.
The study on the extraction, purification, and characterization of mangiferin showed an evaluation of antibacterial activity using serial dilutions with a maximum concentration of 1000 µg/mL [3]. Mangiferin was obtained using ultrasonic extraction with ethanol, and purification was conducted by liquid–liquid fractionation and column chromatography. Ultrasound waves at frequencies above 20 kHz destroyed the cell wall and facilitated the release of mangiferin from the cell into ethanol. This method allows for faster extraction of the target substance and an increase in the yield of the product, which makes it cost-effective. Then, the antibacterial activity of pure mangiferin was investigated with the extracts obtained. It showed good results against S. aureus (MIC = 1.95 μg/mL), E. coli, and P. aeruginosa (MIC = 7.81 μg/mL). Kinetic models showed that mangiferin is able to effectively suppress the growth of bacterial cells of all susceptible strains. Thus, S. aureus dies with a three-fold decrease in CFU/mL within 1 h, while E. coli and P. aeruginosa are completely killed within 3 h, which demonstrates the good antistaphylococcal activity of the compound.
Methanolic extracts of Mangifera indica leaves were investigated for showing growth inhibition of S. aureus and E. coli bacteria using the diffusion agar method. Compared with streptomycin control for S. aureus (16.67 mm), the extracts did not show similar results (14.17 mm). Meanwhile, when these extracts were compared with gentamycin for E. coli (17.5 mm), the extracts showed higher antibacterial activity (18.05 mm). The results confirm the traditional use of M. indica in medicine and emphasize its potential as a source of bioactive compounds [25] (Figure 2).

Figure 2.
Plates displaying antibacterial activity of methanolic crude extract from the leaves of Mangifera indica L. for summer. (A) Gram-positive Staphylococcus aureus (ATCC 43300) bacteria against control streptomycin; (B) gram-negative Escherichia coli (ATCC 25922) bacteria against control gentamycin. Reproduced from [25] under the terms of the CC BY 4.0 license. Copyright 2022, The Authors. Published by MDPI AG.
The improved oral absorption of mangiferin by the formulation in niosomes loaded with mangiferin is considered in the work [43]. The thin film hydration method was used to prepare niosomes. Optimization was done using the Box–Behnken experimental design. The solubility of the drug in different solvents was evaluated. The best solubility was in methanol. Span and cholesterol, when dissolved in a methanol:chloroform (1:2) mixture, formed a transparent and continuous film. Mangiferin was separately dissolved in chloroform and then added to the span:cholesterol mixture. The resulting mixture was dried using a rotary vacuum evaporator at 60 °C to obtain a thin film on the bottom of the flask. The film was hydrated to obtain niosomes. The niosome dispersion was maintained at room temperature and sonicated to uniformly reduce the size. The optimized F12 batch showed a minimum particle size of 545 nm and a maximum capture efficiency of 89.1%. The release of mangiferin from niosomes can be described as sustained, as up to 40% of the drug is released in the first 30 min. When tested for antioxidant activity, mangiferin niosomes showed 60% absorption of DPPH radicals, which is consistent with the absorption of pure mangiferin. Niosomes were also effective against E. coli.
It is necessary to note that in addition to its own antibacterial activity, mangiferin also has a synergistic effect when used in combination with antibiotics. In a recent study, mangiferin was considered a possible enhancer for imipenem. NDM-1 is a beta-lactamase that determines the resistance of bacteria to beta-lactam antibiotics, including carbapenems. Besides the fact that mangiferin itself had an inhibitory effect on NDM-1 (IC50 = 30.6 ± 4.4) and beta-lactamase activity (IC50 = 58.02 ± 2.0), it can also act as a potential enhancer of imipenem. In the tests, the compound had FICI = 0.625, which may suggest a synergistic mechanism of action [44].
As a consequence of conducting a literature review, it was observed that some studies [3,25] indicate a possible synergistic effect of mangiferin and cite a specific article [45]. It supposedly indicates synergistic activity with nalidixic acid, ampicillin, tetracycline, and sulfamethoxazole/trimethoprim. However, this article does not confirm the presence of synergistic effects of mangiferin for the studied substances. No additional studies have been conducted on these drugs with mangiferin supplementation.
The data about the antibacterial activity of mangiferin against ESKAPE bacteria are summarized in Table 2.

Table 2.
Antibacterial activity of mangiferin against ESKAPE bacteria.
The antibacterial activity of mangiferin can be compared to that of another natural compound, curcumin. Curcumin is the major active constituent of Curcuma longa L. (turmeric). Their physical and chemical properties are similar; curcumin also has low solubility. It has also shown the ability to inhibit the growth of both Gram-positive and Gram-negative species and anti-biofilm activity. MIC for curcumin values typically range from 125–250 μg/mL against various S. aureus strains [46], whereas these values are improved for mangiferin. Diffusion tests for curcumin against S. aureus show a result of 24.82 ± 0.54 mm [47] compared to 17.2 ± 0.9 for mangiferin.
With P. aeruginosa, the results for curcumin and mangiferin are quite similar. The MIC range for curcumin is 62.5–175 μg/mL [48], whereas for mangiferin, it is 62.5–125 μg/mL.
4. Conclusions
Today, the search for new antimicrobial drugs is an acute problem. Antibiotics, which are the main choice for treating infections caused by bacteria, are losing their effectiveness due to the emergence and spread of resistant strains. The strains that are resistant to multiple antibiotics, such as ESKAPE, are the most dangerous. They were cultivated in a hospital environment with constant exposure to antibiotics in various concentrations. The defense mechanisms in bacterial cells are very different. This includes, for example, the production of special enzymes and modifications of bacterial structures.
For the complications caused by such bacterial strains, patients have to use either stronger antibacterial drugs or a combination with other drugs to increase the effectiveness of the therapy. In order to combat bacterial infections and improve the effectiveness of drug therapy, new compounds are being sought that can inhibit the growth of microorganisms. The study of natural compounds may become the most promising area of development.
Mangiferin, which is the main biologically active substance of mango fruits, has various effects: antioxidant, anticancer, and antibacterial. The conducted studies clearly show that mangiferin is able to inhibit the growth of bacterial cells at low concentrations. However, it is important to recognize that the difference in the active ingredients contained in the extracts is often the problem. For example, extracts isolated from plants growing in different regions show different results: There may be differences in the values of MICs for one bacterial strain or in the resistance of different strains. Also, the effectiveness of extracts containing additional bioactive substances isolated together with mangiferin from plant parts is greater than that of pure mangiferin. This is the result of the synergistic action of various components in the extracts. While the antibacterial activity of mangiferin has been repeatedly confirmed by studies conducted by different scientific groups, the mechanisms leading to the inhibition of bacterial cell growth by mangiferin remain poorly understood. Further studies are needed to understand how mangiferin affects the bacterial cell and what defense mechanisms of MDR strains it can overcome.
Despite the active study of mangiferin and its antibacterial properties, there are still many unanswered questions, including: (1) Study of purified mangiferin rather than extracts. When studying extracts, it is impossible to clearly understand the mechanisms and extent of the influence of mangiferin in studies of bacterial activity. Leaf extracts contain many other natural substances that may have similar properties or enhance the effect of mangiferin. (2) More studies of mangiferin antibacterial activity should be provided on a large range of ESKAPE bacterial strains. The most popular are S. aureus and P. aeruginos. The third strain is E. coli, but the question about its ESKAPE group identity remains open. (3) Study of the synergistic effect of mangiferin with other antibiotics. Mangiferin has been shown to independently inhibit the growth of bacterial colonies, but obtaining a synergistic effect is an important goal for improving the quality of antibacterial therapy, especially against highly resistant bacterial lines. At the moment, such studies are few, and work should be done in this direction.
Author Contributions
Conceptualization, S.M. and P.S. (Petr Snetkov); methodology, S.M. and P.S. (Petr Snetkov); validation, V.K.; formal analysis, R.S. and P.S. (Polina Serbun); investigation, R.S. and P.S. (Polina Serbun); resources, P.S. (Petr Snetkov); data curation, P.S. (Petr Snetkov); writing—original draft preparation, P.S. (Polina Serbun); writing—review and editing, S.M. and P.S. (Petr Snetkov); visualization, P.S. (Polina Serbun); supervision, S.M. and P.S. (Petr Snetkov); project administration, P.S. (Petr Snetkov); funding acquisition, P.S. (Petr Snetkov). All authors have read and agreed to the published version of the manuscript.
Funding
This research was funded by the Russian Science Foundation, project number 24-23-00269. Link to information about the project: https://rscf.ru/en/project/24-23-00269/, accessed on 26 April 2025.
Institutional Review Board Statement
Not applicable.
Informed Consent Statement
Not applicable.
Data Availability Statement
No new data were created or analyzed in this study. Data sharing is not applicable to this article.
Conflicts of Interest
The authors declare no conflicts of interest.
References
- Matkowski, A.; Kus, P.; Goralska, E.; Wozniak, D. Mangiferin—A Bioactive Xanthonoid, Not Only from Mango and Not Just Antioxidant. MRMC 2013, 13, 439–455. [Google Scholar]
- Kim, H.; Kim, H.; Mosaddik, A.; Gyawali, R.; Ahn, K.S.; Cho, S.K. Induction of Apoptosis by Ethanolic Extract of Mango Peel and Comparative Analysis of the Chemical Constitutes of Mango Peel and Flesh. Food Chem. 2012, 133, 416–422. [Google Scholar] [CrossRef] [PubMed]
- Yehia, R.S.; Altwaim, S.A. An Insight into In Vitro Antioxidant, Antimicrobial, Cytotoxic, and Apoptosis Induction Potential of Mangiferin, a Bioactive Compound Derived from Mangifera indica. Plants 2023, 12, 1539. [Google Scholar] [CrossRef]
- Imran, M.; Arshad, M.S.; Butt, M.S.; Kwon, J.-H.; Arshad, M.U.; Sultan, M.T. Mangiferin: A Natural Miracle Bioactive Compound against Lifestyle Related Disorders. Lipids. Health Dis. 2017, 16, 84. [Google Scholar] [CrossRef] [PubMed]
- Li, L.; Song, L.; Liu, X.; Gao, S. Full Chemical Synthesis Method for Mangiferin Aglycones. CN102002031B, 15 February 2012. [Google Scholar]
- Zhang, W.; Li, P.; Gong, Y.; Gao, X. Mangiferin Aglycone Crystal Form i and Preparation Method Thereof. EP2716637A4, 3 December 2014. [Google Scholar]
- Lei, J.; Zhou, C.; Hu, H.; Hu, L.; Zhao, M.; Yang, Y.; Chuai, Y.; Ni, J.; Cai, J. Mangiferin Aglycone Attenuates Radiation-induced Damage on Human Intestinal Epithelial Cells. J. Cell. Biochem. 2012, 113, 2633–2642. [Google Scholar] [CrossRef] [PubMed]
- Wu, Z.; Wei, G.; Lian, G.; Yu, B. Synthesis of Mangiferin, Isomangiferin, and Homomangiferin. J. Org. Chem. 2010, 75, 5725–5728. [Google Scholar] [CrossRef]
- Gold-Smith, F.; Fernandez, A.; Bishop, K. Mangiferin and Cancer: Mechanisms of Action. Nutrients 2016, 8, 396. [Google Scholar] [CrossRef]
- Bhattacharyya, S.; Ahmmed, S.M.; Saha, B.P.; Mukherjee, P.K. Soya Phospholipid Complex of Mangiferin Enhances Its Hepatoprotectivity by Improving Its Bioavailability and Pharmacokinetics: Mangiferin-HSPC Complex for Better Hepatoprotectivity. J. Sci. Food Agric. 2014, 94, 1380–1388. [Google Scholar] [CrossRef] [PubMed]
- Sarfraz, M.; Khan, A.; Batiha, G.E.S.; Akhtar, M.F.; Saleem, A.; Ajiboye, B.O.; Kamal, M.; Ali, A.; Alotaibi, N.M.; Aaghaz, S.; et al. Nanotechnology-Based Drug Delivery Approaches of Mangiferin: Promises, Reality and Challenges in Cancer Chemotherapy. Cancers 2023, 15, 4194. [Google Scholar] [CrossRef]
- Agarwala, S.; Rao, B.N.; Mudholkar, K.; Bhuwania, R.; Satish Rao, B.S. Mangiferin, a Dietary Xanthone Protects against Mercury-induced Toxicity in HepG2 Cells. Environ. Toxicol. 2012, 27, 117–127. [Google Scholar] [CrossRef]
- Kasbe, P.; Jangra, A.; Lahkar, M. Mangiferin Ameliorates Aluminium Chloride-Induced Cognitive Dysfunction via Alleviation of Hippocampal Oxido-Nitrosative Stress, Proinflammatory Cytokines and Acetylcholinesterase Level. J. Trace Elem. Med. Biol. 2015, 31, 107–112. [Google Scholar] [CrossRef] [PubMed]
- Saleh, S.; El-Maraghy, N.; Reda, E.; Barakat, W. Modulation of Diabetes and Dyslipidemia in Diabetic Insulin-Resistant Rats by Mangiferin: Role of Adiponectin and TNF-α. An. Acad. Bras. Ciênc. 2014, 86, 1935–1948. [Google Scholar] [CrossRef] [PubMed]
- Rahmani, A.H.; Almatroudi, A.; Allemailem, K.S.; Alharbi, H.O.A.; Alwanian, W.M.; Alhunayhani, B.A.; Algahtani, M.; Theyab, A.; Almansour, N.M.; Algefary, A.N.; et al. Role of Mangiferin in Management of Cancers through Modulation of Signal Transduction Pathways. Biomedicines 2023, 11, 3205. [Google Scholar] [CrossRef] [PubMed]
- Rajendran, P.; Rengarajan, T.; Nandakumar, N.; Divya, H.; Nishigaki, I. Mangiferin in Cancer Chemoprevention and Treatment: Pharmacokinetics and Molecular Targets. J. Recept. Sig. Transd. 2015, 35, 76–84. [Google Scholar] [CrossRef]
- Asif, A.; Farooq, U.; Akram, K.; Hayat, Z.; Shafi, A.; Sarfraz, F.; Sidhu, M.A.I.; Rehman, H.; Aftab, S. Therapeutic Potentials of Bioactive Compounds from Mango Fruit Wastes. Trends. Food Sci. Tech. 2016, 53, 102–112. [Google Scholar] [CrossRef]
- Zou, T.; Wu, H.; Li, H.; Jia, Q.; Song, G. Comparison of Microwave-assisted and Conventional Extraction of Mangiferin from Mango (M. Angifera Indica L.) Leaves. J. Sep. Sci. 2013, 36, 3457–3462. [Google Scholar] [CrossRef]
- Kavitha, M.; Nataraj, J.; Essa, M.M.; Memon, M.A.; Manivasagam, T. Mangiferin Attenuates MPTP Induced Dopaminergic Neurodegeneration and Improves Motor Impairment, Redox Balance and Bcl-2/Bax Expression in Experimental Parkinson’s Disease Mice. Chem.-Biol. Interact. 2013, 206, 239–247. [Google Scholar] [CrossRef]
- Cheng, Z.-Q.; Yang, D.; Ma, Q.-Y.; Yi, X.-H.; Zhou, J.; Zhao, Y.-X. A New Benzophenone from Dobinea Delavayi. Chem. Nat. Compd. 2013, 49, 46–48. [Google Scholar] [CrossRef]
- Chomchoei, N.; Leelapornpisid, P.; Tipduangta, P.; Sangthong, P.; Papan, P.; Sirithunyalug, B.; Samutrtai, P. Potential of Electro-Sprayed Purified Mangiferin Nanoparticles for Anti-Aging Cosmetic Applications. RSC Adv. 2023, 13, 34987–35002. [Google Scholar] [CrossRef]
- Kammalla, A.K.; Ramasamy, M.K.; Inampudi, J.; Dubey, G.P.; Agrawal, A.; Kaliappan, I. Comparative Pharmacokinetic Study of Mangiferin After Oral Administration of Pure Mangiferin and US Patented Polyherbal Formulation to Rats. AAPS PharmSciTech 2015, 16, 250–258. [Google Scholar] [CrossRef]
- Irshad, N.; Naeem, H.; Shahbaz, M.; Imran, M.; Mujtaba, A.; Hussain, M.; Abdulmonem, W.A.; Alsagaby, S.A.; Yehuala, T.F.; Abdelgawad, M.A.; et al. Mangiferin: An effective agent against human malignancies. Food Sci. Amp. Nutrition 2024, 12, 7137–7157. [Google Scholar] [CrossRef] [PubMed]
- Sahoo, B.K.; Zaidi, A.H.; Gupta, P.; Mokhamatam, R.B.; Raviprakash, N.; Mahali, S.K.; Manna, S.K. A Natural Xanthone Increases Catalase Activity but Decreases NF-Kappa B and Lipid Peroxidation in U-937 and HepG2 Cell Lines. Eur. J. Pharmacol. 2015, 764, 520–528. [Google Scholar] [CrossRef]
- Maharaj, A.; Naidoo, Y.; Dewir, Y.H.; Rihan, H. Phytochemical Screening, and Antibacterial and Antioxidant Activities of Mangifera indica L. Leaves. Horticulturae 2022, 8, 909. [Google Scholar] [CrossRef]
- Taiwo, B.J.; Miller, A.H.; Fielding, A.J.; Sarker, S.D.; Van Heerden, F.R.; Fatokun, A.A. Ceibinin, a new positional isomer of mangiferin from the inflorescence of Ceiba pentandra (Bombacaceae), elicits similar antioxidant effect but no anti-inflammatory potential compared to mangiferin. Heliyon 2024, 10, e23335. [Google Scholar] [CrossRef]
- Alberdi, E.; Sánchez-Gómez, M.; Ruiz, A.; Cavaliere, F.; Ortiz-Sanz, C.; Quintela-López, T.; Capetillo-Zarate, E.; Solé-Domènech, S.; Matute, C. Mangiferin and Morin Attenuate Oxidative Stress, Mitochondrial Dysfunction, and Neurocytotoxicity, Induced by Amyloid Beta Oligomers. Oxid. Med. Cell. Longev. 2018, 1, 2856063. [Google Scholar] [CrossRef] [PubMed]
- Das, S.; Nageshwar Rao, B.; Satish Rao, B.S. Mangiferin Attenuates Methylmercury Induced Cytotoxicity against IMR-32, Human Neuroblastoma Cells by the Inhibition of Oxidative Stress and Free Radical Scavenging Potential. Chem.-Biol. Interact. 2011, 193, 129–140. [Google Scholar] [CrossRef] [PubMed]
- Lum, P.T.; Sekar, M.; Seow, L.J.; Shaikh, M.F.; Arulsamy, A.; Retinasamy, T.; Gan, S.H.; Gnanaraj, C.; Esa, N.M.; Ramachawolran, G.; et al. Neuroprotective potency of mangiferin against 3-nitropropionic acid induced Huntington’s disease-like symptoms in rats: Possible antioxidant and anti-inflammatory mechanisms. Front. Pharmacol. 2023, 14, 1189957. [Google Scholar] [CrossRef]
- Tiwari, P.C.; Chaudhary, M.J.; Pal, R.; Nath, R. Role of Nitric Oxide Modulators in Neuroprotective Effects of Mangiferin in 6-Hydroxydopamine-induced Parkinson’s Disease in Rats. Ann. Neurosci. 2023, 31, 186–203. [Google Scholar] [CrossRef] [PubMed]
- Rajendran, P.; Ekambaram, G.; Sakthisekaran, D. Cytoprotective Effect of Mangiferin on Benzo(a)pyrene-Induced Lung Carcinogenesis in Swiss Albino Mice. Basic. Clin. Pharma. Tox. 2008, 103, 137–142. [Google Scholar] [CrossRef] [PubMed]
- Park, C.; Cha, H.-J.; Hwangbo, H.; Bang, E.J.; Kim, H.-S.; Yun, S.J.; Moon, S.K.; Kim, W.-J.; Kim, G.-Y.; Lee, S.-O.; et al. Activation of Heme Oxygenase-1 by Mangiferin in Human Retinal Pigment Epithelial Cells Contributes to Blocking Oxidative Damage. Biomol. Ther. 2024, 32, 329–340. [Google Scholar] [CrossRef] [PubMed]
- Zhang, B.; Zhao, J.; Li, S.; Yang, L.; Zeng, L.; Chen, Y.; Fang, J. Mangiferin Activates Nrf2-Antioxidant Response Element Signaling without Reducing the Sensitivity to Etoposide of Human Myeloid Leukemia Cells in Vitro. Acta Pharmacol. Sin. 2014, 35, 257–266. [Google Scholar] [CrossRef] [PubMed]
- Soesanto, S.; Hepziba, E.R.; Yasnill; Widyarman, A.S. The Antibacterial and Antibiofilm Effect of Amoxicillin and Mangifera indica L. Leaves Extract on Oral Pathogens. Contemp. Clin. Dent. 2023, 14, 14. [Google Scholar] [CrossRef]
- Kučuk, N.; Primožič, M.; Kotnik, P.; Knez, Ž.; Leitgeb, M. Mango Peels as an Industrial By-Product: A Sustainable Source of Compounds with Antioxidant, Enzymatic, and Antimicrobial Activity. Foods 2024, 13, 553. [Google Scholar] [CrossRef] [PubMed]
- Emeka, P.M.; Badger-Emeka, L.I.; Ibrahim, H.-I.M.; Thirugnanasambantham, K.; Hussen, J. Inhibitory Potential of Mangiferin on Glucansucrase Producing Streptococcus mutans Biofilm in Dental Plaque. Appl. Sci. 2020, 10, 8297. [Google Scholar] [CrossRef]
- Nortje, N.Q.; Aribisala, J.O.; Pillay, C.; Sabiu, S. Molecular modelling and experimental validation of mangiferin and its related compounds as quorum sensing modulators of Pseudomonas aeruginosa. Arch. Microbiol. 2025, 207, 53. [Google Scholar] [CrossRef]
- Miller, W.R.; Arias, C.A. ESKAPE Pathogens: Antimicrobial Resistance, Epidemiology, Clinical Impact and Therapeutics. Nat. Rev. Microbiol. 2024, 22, 598–616. [Google Scholar] [CrossRef]
- De Oliveira, D.M.; Forde, B.M.; Kidd, T.J.; Harris, P.N.; Schembri, M.A.; Beatson, S.A.; Paterson, D.L.; Walker, M.J. Antimicrobial Resistance in ESKAPE Pathogens. Clin. Microbiol. Rev. 2020, 33, e00181-19. [Google Scholar] [CrossRef] [PubMed]
- Lakhundi, S.; Zhang, K. Methicillin-Resistant Staphylococcus aureus: Molecular Characterization, Evolution, and Epidemiology. Clin. Microbiol. Rev. 2018, 31, e00020-18. [Google Scholar] [CrossRef]
- Høiby, N.; Bjarnsholt, T.; Givskov, M.; Molin, S.; Ciofu, O. Antibiotic Resistance of Bacterial Biofilms. Int. J. Antimicrob. Agents. 2010, 35, 322–332. [Google Scholar] [CrossRef]
- Nguyen, H.T.; Miyamoto, A.; Hoang, H.T.; Vu, T.T.T.; Pothinuch, P.; Nguyen, H.T.T. Effects of Maturation on Antibacterial Properties of Vietnamese Mango (Mangifera Indica) Leaves. Molecules 2024, 29, 1443. [Google Scholar] [CrossRef]
- Sabale, V.; Ingole, A.; Darokar, V.; Sabale, P. Formulation and Characterization of Mangiferin Loaded Niosomes for Oral Delivery. Proc. Natl. Acad. Sci. India Sect. B Biol. Sci. 2024, 95, 197–205. [Google Scholar] [CrossRef]
- Vasudevan, A.; Kesavan, D.K.; Wu, L.; Su, Z.; Wang, S.; Ramasamy, M.K.; Hopper, W.; Xu, H. In Silico and In Vitro Screening of Natural Compounds as Broad-Spectrum β -Lactamase Inhibitors against Acinetobacter baumannii New Delhi Metallo-β-lactamase-1 (NDM-1). BioMed Res. Int. 2022, 1, 4230788. [Google Scholar] [CrossRef] [PubMed]
- Mazlan, N.A.; Azman, S.; Ghazali, N.F.; Yusri, P.Z.S.; Idi, H.M.; Ismail, M.; Sekar, M. Synergistic Antibacterial Activity of Mangiferin with Antibioticsagainst Staphylococcus aureus. Drug Invent. Today 2019, 12, 14–17. [Google Scholar]
- El Oirdi, M.; Farhan, M. Clinical Trial Findings and Drug Development Challenges for Curcumin in Infectious Disease Prevention and Treatment. Life 2024, 14, 1138. [Google Scholar] [CrossRef]
- Hettiarachchi, S.S.; Perera, Y.; Dunuweera, S.P.; Dunuweera, A.N.; Rajapakse, S.; Rajapakse, R.M.G. Comparison of Antibacterial Activity of Nanocurcumin with Bulk Curcumin. ACS Omega 2022, 7, 46494–46500. [Google Scholar] [CrossRef]
- Vladkova, T.G.; Smani, Y.; Martinov, B.L.; Gospodinova, D.N. Recent Progress in Terrestrial Biota Derived Antibacterial Agents for Medical Applications. Molecules 2024, 29, 4889. [Google Scholar] [CrossRef]
Disclaimer/Publisher’s Note: The statements, opinions and data contained in all publications are solely those of the individual author(s) and contributor(s) and not of MDPI and/or the editor(s). MDPI and/or the editor(s) disclaim responsibility for any injury to people or property resulting from any ideas, methods, instructions or products referred to in the content. |
© 2025 by the authors. Licensee MDPI, Basel, Switzerland. This article is an open access article distributed under the terms and conditions of the Creative Commons Attribution (CC BY) license (https://creativecommons.org/licenses/by/4.0/).